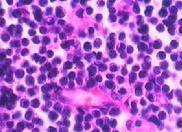

浆细胞白血病(plasma cell leukemia,PCL)属少见类型的急性白血病。浆细胞白血病分为两类:原发性浆细胞白血病和继发性浆细胞白血病。
- 外文名:
- 就诊科室:血液内科
- 传染性:无
- 多发群体:
- 常见病因:
- 常见症状:淋巴结肿大、贫血、脾肿大、肝肿大、继发感染、溶骨性损害、意识障碍、体重减轻、骨髓浆细胞增多
- 人气指数: 人
- 更新日期:2023.11.24 09:29
- 疾病介绍
版权声明:
1、本站内容仅做参考,不能作为诊断及医疗的依据!
2、本文内容来源于网络或会员发布,版权归原网站所有。
3、本站仅提供信息展示,不承担相关法律责任。